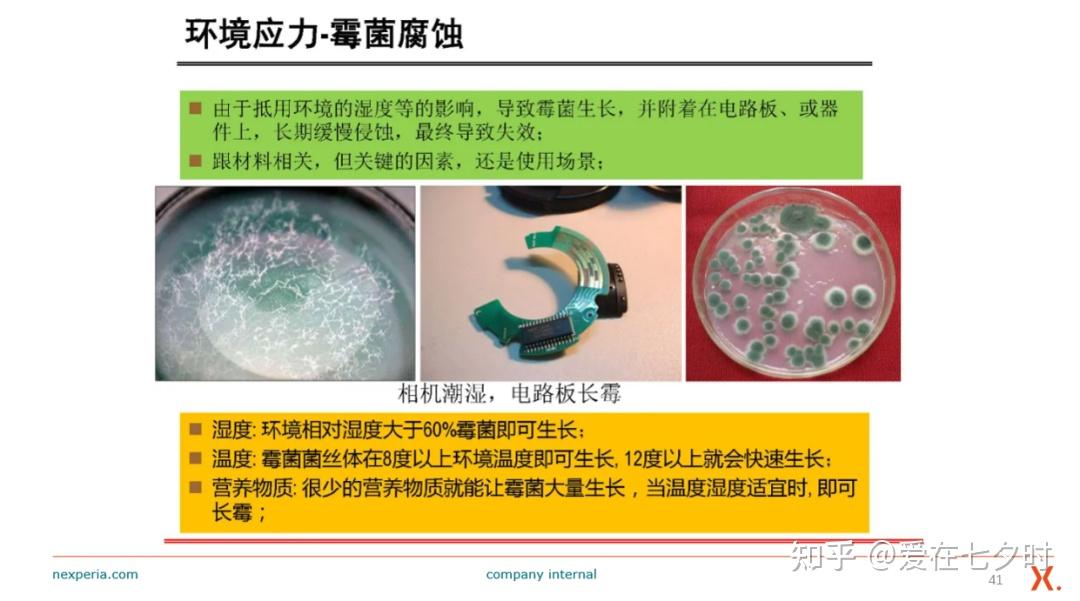
wKgZPGkFuWKAJPqGAAEr8R0aka0888.jpg

【博主简介】本人“爱在七夕时”,系一名半导体行业质量管理从业者,旨在业余时间不定期的分享半导体行业中的:产品质量、失效分析、可靠性分析和产品基础应用等相关知识。常言:真知不问出处,所分享的内容如有雷同或是不当之处,还请大家海涵,当前在各网络平台上均以此昵称为ID跟大家一起交流学习!

失效分析(FA)技术是一门发展中的新兴学科,近年开始从军工向普通企业普及。它一般根据失效模式和现象,通过分析和验证,模拟重现失效的现象,找出失效的原因,挖掘出失效的机理的活动。在提高产品质量,技术开发、改进,产品修复及仲裁失效事故等方面具有很强的实际意义。
失效分析(FA)是对已失效的芯片或模块产品进行的一种事后检查。根据需要,使用电测试及必要的物理、化学分析技术,来探究和验证所报告的失效行为,确定其失效模式、找出失效机理。
所以,失效分析(FA)的目的就是明确失效机理、查找失效原因、提出改进措施、从而提高产品最终的可靠性。其方法分为有损分析,无损分析,物理分析,化学分析等。
一、失效分析技术的概述
随着科学技术的飞速发展,机械产品的品种、数量不断增加,各种产品的功能虽然千差万别,但都有一个共同的属性——具有某种规定的功能。例如,汽车的功能是载重和运输;机床的功能是加工零件等。出于种种原因,机械产品失去其原有的功能的现象时常发生。按照国际通用的定义,“产品丧失其规定功能的现象称为失效”。而机械产品在何时、以何种方式发生失效,是随机事件,人们完全无法预料。机械产品的失效是经常发生的,某些失效往往会带来灾难性的破坏,造成人民生命和经济财产的巨大损失,这在国内外工业发展史上屡见不鲜。例如:
1986年1月28日,美国佛罗里达州的卡纳维拉尔角上空,刚刚升空73秒的挑战者号航天飞机突然发生爆炸,事件造成7名宇航员全部遇难,给美国航天事业带来了沉痛的打击。类似的案例数不胜数。从以上事例可以看出,失效不仅威胁人们的生命安全,同时带来巨大的经济损失。

失效分析是分析引起机械产品失效的原因,并提出对策,以防止其在发生的技术活动和管理活动。
分析引起产品失效的原因是失效分析的核心。失效产品的残骸就是失效分析的客观依据,通过失效分析工作,可以从残骸上找到被“记录”下的失效信息,迅速而准确地找到产品失效的原因,并采取有效措施。实际面对的失效往往是多层次的,通过较明显的失效现象,找到更深入的失效原因,如此往复,最终确定引起失效的根本原因。各层次失效原因的分析均属于失效分析的范畴,失效分析需要进行到哪一个层次的深度,则需要根据实际需要和情况来确定。
失效分析的目的在于提出对策,以防止同类失效事件再次发生。所谓对策是指在工程上可能采取有效的改进或补救措施。失效分析一方面十分重视满足工程的需要,另一方面在实施改革时还必须兼顾经济利益。
失效分析不仅是技术活动,也是管理活动。据日本质量管理统计资料报道,由于管理不当而造成的失效约占失效总数的70%。只有管理活动与技术活动紧密结合,才能顺利完成任务。
二、失效分析技术的介绍
失效分析,英文全称:Failure Analysis,简称:FA。它是指对已失效器件进行的一种事后检查。即便是高可靠器件或是已经长期稳定供货的产品,也会有偶发失效。这是由于器件与器件之间、批次与批次之间,存在质量一致性的差异。这些差异可能来源于生产过程质量控制、微组装操作的规范执行程度、人员的更换、环境的波动、设备的异常,甚至来源于同种原材料的不同批次。差异是普遍存在且不可避免的,但是由差异而引发的质量问题是可以避免的。通过建立良好的质量体系,从人、机、料、法、环等方面,识别差异、管理差异、控制差异来确保产品的可靠性不受影响。
一旦产品偶发失效,失效分析(FA)环节便开始启动,对失效模式、失效原因和失效机理进行定位,从人、机、料、法、环的角度,层层展开,逐一排查。这种基于质量体系的失效分析(FA),往往需要建立故障分析树或鱼骨图,以便更加有条理地进行失效分析(FA)。故障分析树或鱼骨图的正确展开,首先要做的工作就是对失效现象进行正确的描述,而后才能排查引起这种失效现象可能的原因。依靠经验可以加快失效分析(FA)的进程,有助于快速定位问题的根源,但经验有时也会蒙蔽发现问题的眼睛,无法发现相近的失效现象背后的微小差别。这样,同样的质量问题在下一个批次中还会发生,从而给人们带来血淋淋的一教训。失效分析(FA)的目的,是找到问题的本质,确定失效模式和失效机理,提出有效的改进措施,提高成品率和可靠性。进一步,要做到举一反三。
失效分析(FA)技术是电子封装领域一种常用的分析手段。当器件完全丧失功能、功能衰退或失去可靠性与安全性时,需要通过失效分析(FA)来研究失效机理、失效模式,找到解决和预防措施。
有人提出,器件一旦失效,千万不要敬而远之,而是如获至宝。这是因为,失效器件携带着宝贵的缺陷信息,这些缺陷信息是设计、制造过程中的矛盾、不适应、不合理问题的最直接反映。创根问底地研究这些缺陷信息,有利于了解封装技术的本质,也有利于学习封装技术中力学、热学、电气学、材料学、机械学等基础原理。
三、失效分析(FA)的表现层次
半导体器件的失效可以根据失效发生的阶段划分为三个层次:
1、设计芯片(裸片)层次
芯片层次的失效是目前出现概率最高的阶段,因为现在芯片工艺与设计的复杂性,工艺偏差,设计不到位等多方面因素,都会造成芯片在制造、运输等过程中发生失效。
2、制程封装层次
封装过程中键合失效,打线过重,粘连失效,空洞过多等因素都会造成封装层次上的失效,随着现在封装技术愈发先进,封装过程中出现失效的风险也在上升。
3、客户应用层次
下游客户在芯片应用端造成的失效。诸如PCB板设计不合理、超出极限的应用场景等,这种情况在我前期分享的文章里就有详细讲解,这里就不再赘述了。

四、失效分析(FA)的主要内容
失效分析的主要内容包括:明确分析对象、确认失效模式、失效定位和机理分析、寻求失效原因、提出预防措施等。
1、明确分析对象
失效分析首先就要明确分析对象及失效发生时的背景,在对失效样品进行具体的失效分析操作之前,需要详细了解失效发生时的状况,使用环境等,同时获得该样品的技术规范和性能指标,学习掌握其工作原理、材料、结构和工艺。
简单来说就是要将芯片失效的“症状”记录下来,诸如短路、开路、漏电、性能异常、功能异常、时好时坏等。很多失效原因其表现出的“症状”是相似的,例如漏电,物理损坏能造成漏电,隔离不到位也能造成漏电,Latch-up问题也会造成漏电。
2、确认失效模式
失效模式是器件失效的外在表现形式。开展失效分析的第一步就是对失效样品的失效现象和模式进行确认,主要是外观检查和电学性能参数的测试分析,有时还需要开展应力试验。确认在交付后的应用端发生失效,还是封装后失效,亦或是裸片自身就有问题。三种不同层次对应不同的失效分析思路。
3、失效定位和机理分析
失效模式确认后,需要对失效发生的区域进行定位。如:正常功能测试中出现失效;高低温测试出现失效;ATE出现失效;ESD失效,封装造成失效。(如果测试工程师能严格遵守静电防护要求进行测试和设计测试板,芯片在测试过程中面临ESD/EOS的风险很低)。
具体就是定位到说明失效机理的层次和区域,如引线键和区域、芯片终端区域、有源区等等。显微观察和结构分析及物理性能探测是进行失效定位的重要手段。失效定位完成后,就要针对失效区域和失效形貌特征,从失效样品的材料、结构、工艺出发,结合失效发生的背景信息对失效机理进行分析。
4、寻找失效原因
确定失效机理后,还需要进行失效原因分析。对于同一失效机理来说,导致失效发生的原因则不一定相同。只有确定失效发生的主要原因后,才能有针对性地预防和改进。
a.要对失效问题进行复现或追查,确认芯片失效原因,从而帮助推测失效原因。
b.对失效类型做出推断,从而确定失效分析的方向。如果无法通过失效结果推断出失效类型,那么只能根据后续的测试结果进行推断。
5、提出预防和改进措施
确定失效原因后,对失效原因有大致推断后就需要进行实验去寻找数据支撑,如果推断比较清晰的话实验就比较好去定位。具体来说应该有针对性地预防和改进措施。这些措施可以从芯片设计、流片工艺、封装过程等等各个环节。
6、总结改善措施
得出失效原因的结论后就需要制定相对应的改善措施,并记录在册。每一次的失效结论都是拿钱砸出来的经验教训,也是产品公司必须要经历的过程。
五、失效分析(FA)技术常见分析方法
失效分析(FA)一般按照先非破坏性分析再破坏性分析的顺序开展。这是因为一旦样品被破坏,就难以还原了,一些可能被忽略掉的信息再也无法追回了。常见的失效分析方法 如下 :
1、非破坏性分析
(1)目检—OM(Optica Microscope)
利用高倍数显微镜对芯片或者封装表面进行视觉检测。观察芯片表面沾污、裂纹、腐蚀,金属外壳绝缘子裂纹,镀层腐蚀、脱落,键合丝缺失、损伤、连接错误等。

(2)电测试
测试器件功能、参数等。
(3)X射线照相—X-Ray/ Computed Tomography (CT) X-Ray
利用X光和CT对芯片进行拍照从而得出内部结构图。如果需要得到更详细的内部结构,可以将样品进行360°拍照,然后利用图像处理技术构建出芯片的3D结构图。X光和CT用于检查键合金丝完整性,焊点与焊盘的焊接情况,密封区、粘片区的空洞问题。

(4)超声扫描—SAT/SAM (Scanning AcousticTomography/Scanning Acoustic Microscopy)
SAT/SAM利用超声波在不同介质中的反射系数,得出封装内部的结构图。通过检测反射波来检测封装结构中的分层、空洞、裂纹等问题。且SAM的精度与分辨率是强于SAT的。

(5)密封
通过粗检漏、细检漏判断器件气密性和漏率。
(6)粒子(颗粒)碰撞噪声检测(PIND)
通过颗粒噪声检测器件内是否存在可动多余物。
(7)内部气氛检测
测量密封器件内部水汽、氧气、二氧化碳等内部气氛的种类及含量。
2、破坏性分析
(1)开盖—Decapsulation
大部分封装所造成失效都能通过上述的非破坏性分析手段检测出来,但是如果需要对芯片进行检测就得去封装(开盖)。目前Decapsulation的手段有两种,即:化学法(利用硫酸和硝酸去腐蚀开盖)和 激光法(利用激光将封装熔解)。

(2)电气故障—EFA (Electrical Failture Analysis )
a、Electrical Testing
利用探针台+半导体分析仪+电学测试设备,利用探针对芯片内部进行采样和施加激励,直接对电路模块进行电学特性分析。这是最普遍的电学失效分析手段,不过探针的扎针落点有很多限制,有时得配合FIB和金属去层才能对指定的模块进行电学性能测量。

b、Photo Emission Microscope (EMMI InGaAs OBIRCH)
其中关于EMMI的部分在之前有分享过,传统EMMI的探头为CCD,而InGaAs是EMMI的一种探头,两者的接收波段有区别,且InGaAs更加快速与灵敏。

OBIRCH是利用红外激光照射局部位置引起热梯度造成局部电阻变化,从而观察到电流变化。阻抗异常其电流变化会与其它地方不同,从而定位失效点。EMMI InGaAs OBIRCH是三种应用非常广泛的FA手段,其结果不如SEM, X-Ray等技术直观,且依赖偏置条件,但是能快速定位失效点,其应用场景远比SEM等广泛,是主流的失效分析手段之一。日后笔者会总结EMMI的分析心得,进行EMMI前最好先对失效点及失效原因有个推断,然后给予适当的偏置条件。
(3)PFA (Physical Failure Analysis)
物理失效分析就需要对芯片进行一些物理处理,其中最主要的处理方式一个是纵刨,一个是金属去层。纵刨的样品制备包括清洗、安装然后将样品放入聚酯或环氧树脂中。

去层工艺使用化学溶液/气体蚀刻和机械抛光来缓慢、精确地去除芯片上的每一层金属。

(4)聚焦离子束—FIB (Focus Ion Beam)
因为FIB聚焦离子束是一种基于高能离子束的微纳加工与分析技术,核心是通过液态金属离子源(多为镓Ga+)产生聚焦离子束,对材料进行纳米级操控,广泛应用于半导体、材料科学、纳米技术等领域。同时,FIB聚焦离子束加工分析技术也是微纳尺度下的“精准操控工具”,兼具加工与分析能力,是现代半导体、材料科学的核心技术之一,所以由于它是IC设计公司最常用的失效分析手段之一,这里就不赘述了。
(5)扫描电子显微镜—SEM(Scanning Electron Microscope )
SEM也是常用手段之一,因为其放大倍数很大,所以利用其他手段确认失效点后便可利用SEM进行直观观察,从而确认失效原因。SEM可以对表面进行观察,也可配合纵刨技术对截面进行观察。
(6)扫描电容显微镜—SCM(Scannin Capacitance Microscope)
扫描电容显微镜,这种显微镜主要是利用探针对半导体器件施加信号,然后测量C-V曲线,从而确定半导体器件的掺杂类型。
而类似AFM、TEM、EDX、XPS、XRD等微观物相测量手段,一般是Fab进行更深层次的失效分析时才会用到,Design House一般不需要介入如此深的物相表征。
(7)红外成像
通过红外成像,观察芯片表面热点位置,判断是否存在击穿、短路等问题。

六、失效分析(FA)技术基础知识培训
以下就是本章节要跟大家分享的关于失效分析(FA)技术基础知识的培训,如有遗漏或是不足之处,希望大家多多包涵,内容如下:

http://weixin.qq.com/r/QhAjO9TE64mUrZBY90VQ (二维码自动识别)
因为本PPT章节太多,剩下部分如有朋友有需要,可私信我邀请您加入我“知识星球”免费下载PDF版本。注意:此资料只可供自己学习,不可传阅,平台有下载记录,切记!欢迎加入后一起交流学习。

七、失效分析(FA)的技术手段
因为失效分析(FA)的工作就是采用各种测试和分析技术,结合失效分析(FA)技术人员的专业背景和工程经验,通过一定的分析程序,对失效进行分析、推理和判断的过程,所以相关的分析技术手段还是挺多,比较常见的如下:
1、失效分析的电气测试技术
主要是对用于失效现象、失效模式进行确认,以及在失效激发及验证试验前后的电性能测试。通过测试可以进行失效的电学定位,缩小物理分析过程和区域,而利用光、热、磁场等进行的物理性能探测也需要电测技术的配合;
2、显微形貌分析技术
这是对功率器件的进行外观和内部检查的技术,是进行失效定位和机理分析的最基本和最重要的手段。因功率芯片在微观结构达到微米甚至纳米级别,所以除了光学显微镜还包括扫描电子显微镜SEM、透射电子显微镜TEM等电子显微分析技术和手段。
3、显微结构分析技术
是指以X射线显微透视、扫描声学显微(SAM)探测等为代表的无损显微结构探测技术。可以在不破坏失效样品的情况下获得器件或模块的内部结构,探测其可能存在的缺陷,如空洞、断线、界面分层、材料裂纹等。
4、物理探测技术
失效定位是决定失效分析是否成功的关键,很多时候仅通过电测或显微形貌和结构观察无法进行准确的失效定位。因器件内部失效区域和缺陷点在应力或粒子激发的条件下可能会出现异常的电压、发光、发热等现象,因此采用探测器件内部的电、光、热等物理性能的方法就可以进行失效定位,具体的技术包括电子束测试EBT、微光探测、显微红外热成像、显微磁感应技术等。
5、微区成分分析技术
器件发生成分变化也会发生失效,多余的杂质玷污也可能是造成失效的原因。因器件的微观结构和微量成分的特点,这种成分分析技术必须是微区和微量。具体有能量散射谱仪EDS、俄歇电子谱法AES、二次离子质谱法SIMS、X射线光电子谱法XPS、傅里叶红外光谱法FT-IR、内部气氛分析法IVA等。
6、应力试验技术
器件失效均与应力有关,这些应力包括温度、湿度、电压、电流、功率、机械振动、机械冲击、恒定加速度、热冲击和温度循环等。因此,在失效分析时,有时就需要开展一些应力试验来激发失效、复现失效模式或观察在应力条件下失效的变化趋势,从而有助于分析失效机理、确定失效原因。
7、解剖制样技术
因功率芯片或模块的封装材料和键合线的不透明性,对于大部分失效分析技术问题,必须采用解剖制样技术,实现芯片表面和内部的可观察性和可探测性。例如开封技术、半导体芯片表面去钝化层和去层间介质层技术、机械剖面制备技术和染色技术。而对于开展TEM分析来说,还需要采用聚焦离子束FIB进行微米甚至纳米尺度的切割和制样。

八、失效分析(FA)技术的发展
随着科学技术的发展和工业水平的提高,失效分析技术在国内越来越受到重视,目前我国各行业的材料工艺及综合性研究所(如中国航发北京航空材料研究院,航空工业综合所,航天材料及工艺研究所,电子五所等);高等院校(如华南理工大学,北京航空航天大学等)的材料学院;各材料工业部及科学院所属的研究机构(钢铁研究总院,有色金属总院,中科院金属所等)以及一些大型企业内部研究单位和中心实验室,均有能力从事一定程度的失效分析工作。总之,我国的失效分析发展的最大特点就是行业特征明显,各大失效分析研究机构较多分布于各行业内部。
1、航空工业综合所在失效分析工作方面具有较强的专业实力。首先,作为一家综合性研究所,通常以第三方身份参与航空装备相关的失效分析工作。其次,航空工业综合所具有较强的综合研究力量,基础研究、应用研究多学科交叉,能够为失效分析工作遇到的多种类学科问题提供坚实的专业支撑。
2、电子元器件失效分析作为可靠性物理的核心内容,在可靠性工程应用中起重要的支撑作用,但失效分析工作对元器件和整机系统来说,作用有所不同。
对元器件生产厂家来说,失效分析的最终目标是提交合格的产品,保证和改进元器件本身的可靠性,满足工程应用需求,并提高竞争力。其析出失效的环节是产品的全寿命周期,包括初样试验、原材料选择、工艺鉴定、生产过程检验、筛选试验、鉴定检验试验、质量一致性检验及用户的试验和现场使用等,而失效分析的目的也是确定失效与其中哪些环节相关,为改进提供依据。
九、写在最后的话
鉴于失效分析的重要作用,应将这项工作贯穿于电子元器件设计、研制、生产、试验和使用全过程,这些技术过程中需要进行失效分析才能得以完成或完善。最简单的道理就是:因为可靠性是以不断地与失效做斗争才能得以维持或提高的,如果对失效的本质不了解,就不能做到知己知彼,就难以获得取胜的条件。
总之,失效分析(FA)技术是连接失效现象与根本原因的关键技术,尤其在硅基新能源、半导体等领域,通过系统性分析可解决“材料/器件为何失效”的核心问题,为产品优化提供依据。如需具体案例分析(如电池或器件失效),可进一步结合材料表征与电学测试数据深入溯源。


免责声明
【我们尊重原创,也注重分享。文中的文字、图片版权归原作者所有,转载目的在于分享更多信息,不代表本号立场,如有侵犯您的权益请及时私信联系,我们将第一时间跟踪核实并作处理,谢谢!】











